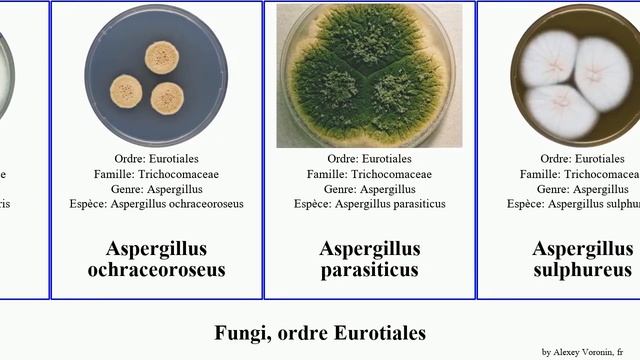
Fungi, ordre Eurotiales aspergillus fungus giganteus parasiticus Penicillium Fuse ochraceoroseus смотреть онлайн

Автор / Канал: Лесные обитатели

...Ножки... )))))

This A.I. ART GENERATOR will blow your mind...

truth of world of tanks

Семья в Америке\закупка продуктов в магазине BeL AiR

Евгений Масленко. Краеведческая неделя Херсона #16

Что делать если у тебя есть велик🚲, а на улице Масленица🥞?

МАЙНЯК В КЭЗГО

Полеты в Джилы-Су

KOMBUCHA PARA BAJAR DE PESO

White Moss | 2015 LA Film Fest

01 09 2021 Грибы ягоды

OMG plantas resistencia a virus bacterias y hongos

Green World Urdu Presentation

Лечение женских заболеваний тампонами Хеппинесс

( Мои стихи № 49 ) Пусть печаль моя погаснет в этот вечер ... 2005 г.
Fungi, ordre Eurotiales aspergillus fungus giganteus parasiticus Penicillium Fuse ochraceoroseus

Куриные зразы с грибами и сыром #зразы #курица #готовим #вкусно #кулинария #рецепты #еда #котлеты

Яичко

НАШЕ ТЕЛО. ВЕБИНАР 28.01.2023

мастерски прохождение Gothic 1,часть 2,угодья.

JRF/SRF/NET- 2022 - General Knowledge - 5 - Organic Farming

A gombák erejével az egészséges növényekért - Tricho Immun, a világraszóló magyar termék

Genius LIVE with Denise Armenio. Topic was Candida Auris - New Strain

всё нет быков.
За каждым успешным каналом стоит личность, идея и сотни часов кропотливого труда. Если вы здесь, значит, автор «Лесные обитатели» уже сумел зацепить ваше внимание своим уникальным стилем или подачей. А мы на RUVIDEO позаботились о том, чтобы вы могли изучить весь архив его работ в максимально комфортных условиях — без лишней суеты и преград.
Почему за работами канала «Лесные обитатели» так интересно наблюдать? Всё просто: это честный контент, который находит отклик в сердцах зрителей. На нашем ресурсе вы можете смотреть онлайн все видео любимого автора бесплатно и в хорошем качестве. Нам важно, чтобы вы видели каждую деталь и слышали каждый нюанс, поэтому мы используем только стабильные плееры из открытых источников Rutube.
Следите за новинками канала, пересматривайте старые шедевры и открывайте для себя новые грани творчества «Лесные обитатели». Мы постоянно обновляем ленту, чтобы у вас под рукой всегда были самые свежие выпуски. Никаких сложных регистраций — только вы и творчество, которое вдохновляет. Приятного вам путешествия по миру авторского контента на RUVIDEO!
Видео взято из открытых источников Rutube. Если вы правообладатель, обратитесь к первоисточнику.